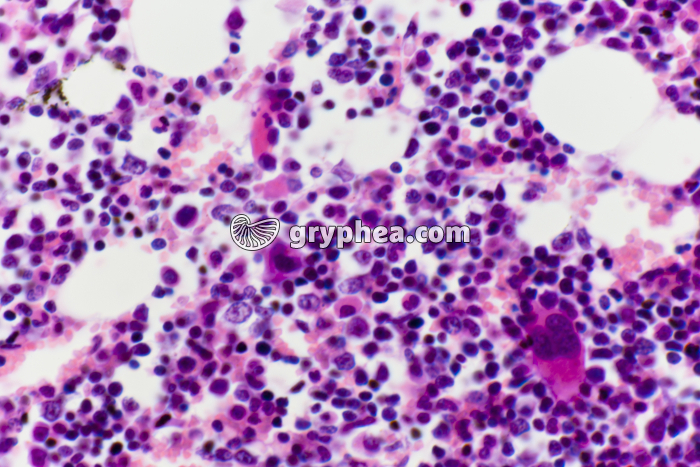
Moëlle osseuse in situ x200 - gryphea.org

Les photographies, infographies, vidéos, sons et textes publiés sur ce site ne sont pas totalement libres de droits. Vous pouvez les utiliser librement à titre personnel, dans la création de vos cours, compte-rendus, diaporamas, en respectant le watermark qui y est inclus, à la condition expresse d'avoir souscrit à un abonnement. Le contrat d’utilisation ne vous autorise cependant pas à diffuser ces documents ailleurs que dans le cadre strict de votre enseignement, et en aucun cas sur les réseaux sociaux. Merci de votre compréhension.
Pour accéder à tous les contenus de gryphea.org, aux photos haute définition et aux vidéos intégrales, profitez de nos offres d'abonnement :
La moelle osseuse présente 2 aspects et 2 localisations différentes : la moelle rouge, responsable de la fabrication des cellules sanguines (globules rouges ou hématies, globules blancs ou leucocytes, et plaquettes sanguines), et la moelle jaune, principalement constituée de tissu adipeux. La moelle osseuse rouge contient les cellules souches hématopoïétiques, capables d’évoluer en n’importe quelle catégorie de cellules sanguines, et des cellules de soutien, les cellules stromales. On la trouve dans l’os spongieux des épiphyses (extrémités) des os longs, des vertèbres et de tous les os plats. La moelle osseuse jaune remplit la cavité centrale et oblongue des os longs, au niveau des diaphyses (partie située entre les épiphyses).
La moelle osseuse rouge est sujette à plusieurs maladies graves, comme les leucémies, la drépanocytose ou les thalassémies. Elle peut être transfusée à des malades lors d’un don de moelle.
La suite du commentaire est réservée aux abonnés